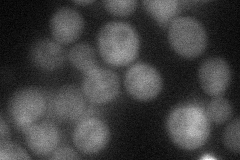
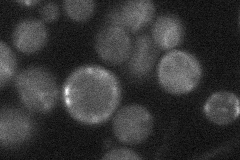

View description
Protein of unknown function, required for survival upon exposure to K1 killer toxin; involved in proteasome-dependent catabolite inactivation of FBPase; contains CTLH domain; plays role in anti-apoptosis
Localization:
Intensity:
Fold change:
Significance:
-
C’ GFP library in SD

nucleus22.04 -
N' NOP1pr-GFP in SD

punctate13.6475 -
N' TEF2pr-mCherry in SD
nucleus28.6625 -
N' NATIVEpr-GFP in SD
below threshold20.7115 -
N' TEF2pr-VC and Cyto-VN in SD

cytosol27.1742 -
C’ GFP library in SD+DTT

nucleus29.161.32Yes -
C’ GFP library in SD+H2O2

nucleus20.110.91No -
C’ GFP library in Starvation Media

nucleus26.71.21No -
C’ GFP library on the background of Pup2-DaMP

nucleus -
C’ GFP library on the background of CCT mutant

nucleus26.24461.19008No
